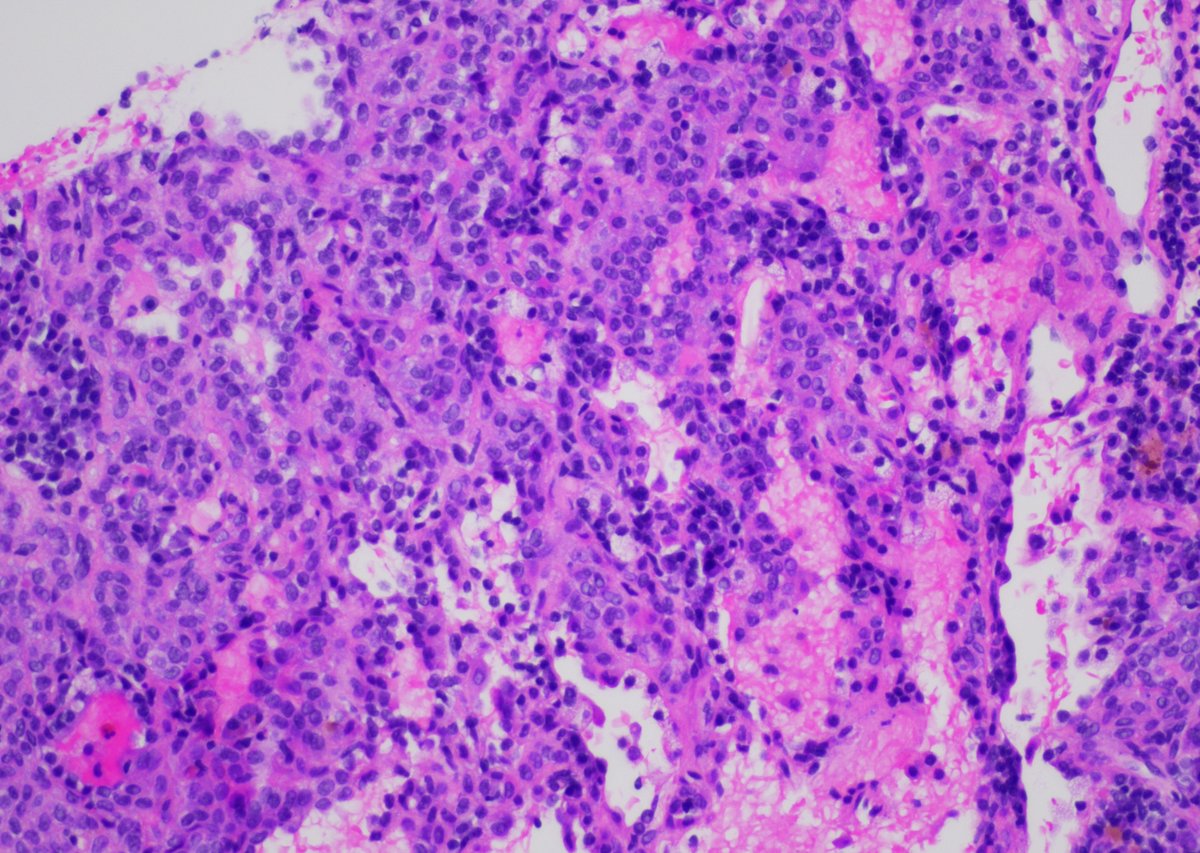
65yo F with 1.3cm LLL lung nodule. Core biopsy of the mass was performed. #pathology #pathtwitter #pulmpath #pathboards <a href="/ChoudhuriJui/">Jui Choudhuri</a> <a href="/ridin_bk_MD/">Ridin Balakrishnan, MD</a> <a href="/pembeoltulu/">Pembe Oltulu, MD</a> <a href="/ariella8/">Celina Stayerman MD</a>  <a href="/DrVish/">Vish Killari MD MPH</a> <a href="/Dr_Brian_Cox/">Brian Cox, MD, MAS</a> <a href="/DrRanasaleh/">Rana Saleh, MD</a> <a href="/ALBoothMD/">Adam L. Booth, MD</a>

Jui Choudhuri
@choudhurijui
@Cytopath fellow, @Hemepath @MontefioreNYC @EinsteinPath | Former training in #TransfusionMedicine #HLA from @CMCVellore @HIMS Dehradun
ID: 1397865817438666752
27-05-2021 10:42:48
72 Tweet
260 Followers
274 Following

Cutaneous Kaposi sarcoma from 35yo M with HIV/AIDS #PathTwitter #pathology #dermpath #dermtwitter #patheducation #infectiousdisease Einstein Montefiore Pathology the New York Pathological Society Brian Cox, MD, MAS Anju Pandey Rebecca M. Marrero Rolon Rebecca Czaja Jerad Gardner, MD Tristan Rutland MBBS FRCPA IFCAP Olaleke Folaranmi


65yo F with 1.3cm LLL lung nodule. Core biopsy of the mass was performed. #pathology #pathtwitter #pulmpath #pathboards Jui Choudhuri Ridin Balakrishnan, MD Pembe Oltulu, MD Celina Stayerman MD Vish Killari MD MPH Brian Cox, MD, MAS Rana Saleh, MD Adam L. Booth, MD

24yo F, 2cm wrist lesion. #pathology #pathtwitter #BSTpath #pathboards Einstein Montefiore Pathology @histiocytosisX Jason L. Hornick, M.D., Ph.D. Tristan Rutland MBBS FRCPA IFCAP Brian Cox, MD, MAS Vish Killari MD MPH Celina Stayerman MD Adam L. Booth, MD Jerad Gardner, MD Olaleke Folaranmi



Pre-auricular nodule x 1month from 31yo patient, no other complaint. #pathtwitter #surgpath #ENTpath #hemepath #pathboards Einstein Montefiore Pathology Ridin Balakrishnan, MD Hansini Laharwani Siba El Hussein, MD Mitul B. Modi, MD Tristan Rutland MBBS FRCPA IFCAP Jerad Gardner, MD Kamran Mirza MD PhD - کامران مرزا





63/male with abdominal lymphadenopathy. DQ gave the initial clue to hemepath diagnosis. Positive CD3/5/7/25. CD30 diffuse, ALK1/CD20 negative. CD30+ Mature T-cell lymphoma. D/D ALCL or ATLL HTLV1 is positive! #cyto #hemepath #PathTwitter Kevin Kuan Yanhua Wang #bridgingcytoheme










Metastatic GIST to an abdominal lymph node- With both epithelioid and spindle cell features. Positive for DOG1, CD34 and CD117(shown here). #pathtwitter #cytology #surgpath #path Kevin Kuan


ACT EARLY, ACT NOW Join Us! Salud Es Vida! FREE Screening Day for #BreastCancer & #CervicalCancer No Insurance or Govt Docs Needed Sat. May 18, 9A to 2P; 3400 Bainbridge Ave, #Bronx Please help spread the word! Register Eventbrite at tinyurl.com/2rvventb or call 718.430.3613













